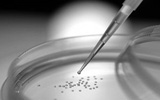
2014年转化医学领域十大科技突破

2014,食品健康的谣言与忽悠20强
我们的生活中从来不缺乏谣言。谣言的产生和传播远远比辟谣来得迅猛。2014年即将过去,让我们来盘点一下这一年中食品领域的20个主要谣言与忽悠。
华西开放六种资源 响应国家分级医疗方略
为了响应国家分级诊疗方略,构建实质性医院联盟,华西医院将向新的联盟医院开放6种资源,涵盖医教研和品牌等各个方面。
《科学》预测2015年科研热点(生物类)
Science杂志公布了2015年值得关注的科研热点,也就是在未来一年内有可能出成果的研究方向。这包括北极海冰,复合免疫疗法,干细胞制备等。
Nature公布2014年度十大最热新闻(生物
2014年科学领域充斥着各种大起大落,就像一次次惊心动魄的过山车。Nature杂志日前公布了杂志上最受读者关注的十大新闻,涵盖了物理、生物、医学等多个方面。我们在此摘取了生物类新闻以飨读者。
权威调研预测:2020年全球20大孤儿药
根据全球领先的医疗健康领域行业及市场调研公司EvaluatePharma近期发布的数据估计,到2020年,全球孤儿药市场价值或将达到1760亿美元,接近处方药销售总额的19%。
2014生物医药界十大热词盘点
今年的转化医学领域格外热闹,而来自这个行业的社会热点事件,已经不再专属于某一个小圈子,而是已经辐射于整个社会。
2014:京沪两地医学检验所盘点
医学检验具有不可估量的市场潜力。截至2014年底,京沪两地医学检验所各达28家,详情请看转化医学网的盘点。
盘点2014:转化医学领域八大黑天鹅事件
我们盘点2014年的转化医学领域黑天鹅事件,盘点每一个令人或悲伤或愤懑的热点事件。希望能唤起一份对大自然的敬畏,并从孕育黑天鹅事件的看似平淡如水的日子里,省察祸患的端倪。
2014哪些医药健康类企业上市了?
企业上市,能广泛吸收社会资金,迅速扩大企业规模,提升企业知名度,增强企业竞争力。世界知名大企业,几乎都是通过上市融资,进行资本运作,实现规模的裂变,迅速跨入大型企业的行列。 近几年,医药健康界正风起云涌,业内公司竞相上市,在此,我们为大家盘点了2014年陆续上市的医药健康领域公司:
【地方篇】转化医学中心盘点,你的老家有吗?
转化医学越来越受到世界的关注,已经成为世界医学研究的一个新的起步点和着力点。 近两年,我国对转化医学也越来越重视,全国各地相继成立转化医学中心,在此,我们为大家盘点了全国各地(上海、北京除外)的转化医学中心,详见下文:
2014年转化医学领域十大科技突破
2014,是医疗技术厚积薄发的一年,这一年,学者们和各大公司为我们带来了太多的惊喜,但是小编相信,在大家的齐心努力下,2015,将会是成果更为辉煌的一年。
你可知道,DNA也需要自己的互联网
近日,遗传学家与程序员组成基因组学与健康全球联盟,联合开发互联网DNA信息交互的协议。这一成果将可与HTTP传输协议对网络的重要性相比。
医药行业深度研究报告:体外诊断--国产品技术进
从行业整体看,受益于医保覆盖面的提升及医院诊断技术的升级,国内体外诊断产业近年来整体快速成长(复合增速超过20%),2013年市场规模预计已达250亿元左右。从细分行业看,生化、化学发光免疫、血细胞等主流细分行业由于所处的发展阶段不同其增长前景也各不相同。
远程医疗另辟蹊径:B2B端定位急症和小医院
远程医疗在中国受到政策限制,只能以机构之间的名义展开。虽然说B2C端的远程医疗暂时有瓶颈,但其实从国外的远程医疗发展来看,B2B端的远程医疗如果操作得当,短期内的医疗效果和控制成本的能力反而更强。这对中国未来远程医疗的发展也是一个很好的借鉴。
“微医疗”发威 需跨三道坎
“微时代”正迎来它的“威时代”。去年11月,腾讯微信产品部负责人披露,微信公众号正以每日8000个的速度增长。伴随着铺天盖地的微信大潮同时体现的,却是潜力尚未被挖掘的庞大市场。自去年起,众多医疗机构也试水“微医疗”,纷纷推出微信平台。
未来5年全球远程健康市场将翻倍增长
分析预测2014~2019年间,远程健康市场将以18.88的年复合增长率增长。报告的研究对象主要是使用IT和电子通讯技术来提供医疗服务的企业,这些应用包括使用视频会议、电子邮件、智能手机、无线设备工具以及其他方式的远程沟通领域的技术。
2015连锁药店的突破点
这几年,连锁药店行业基本呈现弱增长状态,无论是医改政策的利好、大健康产业的强劲势头或是互联网工具的应用,都没能改变目前这一现状。同时,连锁药店又面临新版GSP认证大限和执业药师的匮乏,房租、人工成本增加及被兼并的威胁,那么,2015年连锁药店将如何扭转和突破?
栏目推荐
| 第五届单细胞技术应 |
| 【快讯】翌圣生物完 |
 腾讯登录
腾讯登录